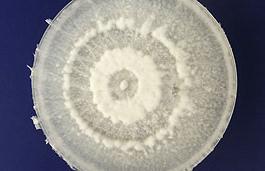

El “Síndrome de Peter Pan” se extiende en el mundo
Se trata de aquellas personas que se niegan a abandonar la adolescencia. En algunos países los llaman “solteros parásitos”. Una especialista explicó a qué se debe esta actitud y qué se esconde en su...
Insólito – Familia sin huellas dactilares
Una familia suiza, cuyos miembros nacen dese hace generaciones sin ningún tipo de marca en sus dedos, palmas y plantas del pie, han sorprendió a todo el mundo.
Los estudios exhaustivos sobre la familia han permitido...
La NASA financia 30 nuevos proyectos de investigación espacial
La agencia espacial de EEUU (la NASA) anunció el lunes la financiación de 30 nuevos proyectos, entre ellos, cómo proteger a los astronautas de la radiación en el espacio, cómo eliminar los desechos espaciales y...
Estudiantes descubren un hongo que degrada plástico
El viaje de un grupo de estudiantes a la Amazonia tuvo un resultado inesperado y potencialmente revolucionario: el descubrimiento de un hongo que puede descomponer o degradar plástico.
Los alumnos, del departamento...
Maquinilla de afeitar con forma de tarjeta de credito
Esta maquinilla de afeitar esta camuflada de forma que parece una tarjeta de credito normal y corriente que puedes llevar en la cartera. La idea es que puedas conseguirte un afeitado de emergencia en cualquier momento y...
El intrépido hombre araña ruso
El Hombre Araña ruso. Sergey Devliashov es un joven que desafía las alturas en Tyumen y registra sus hazañas en YouTube
El futuro Garfield. Esta mascota se tomó en serio la personificación del famoso gato y se...